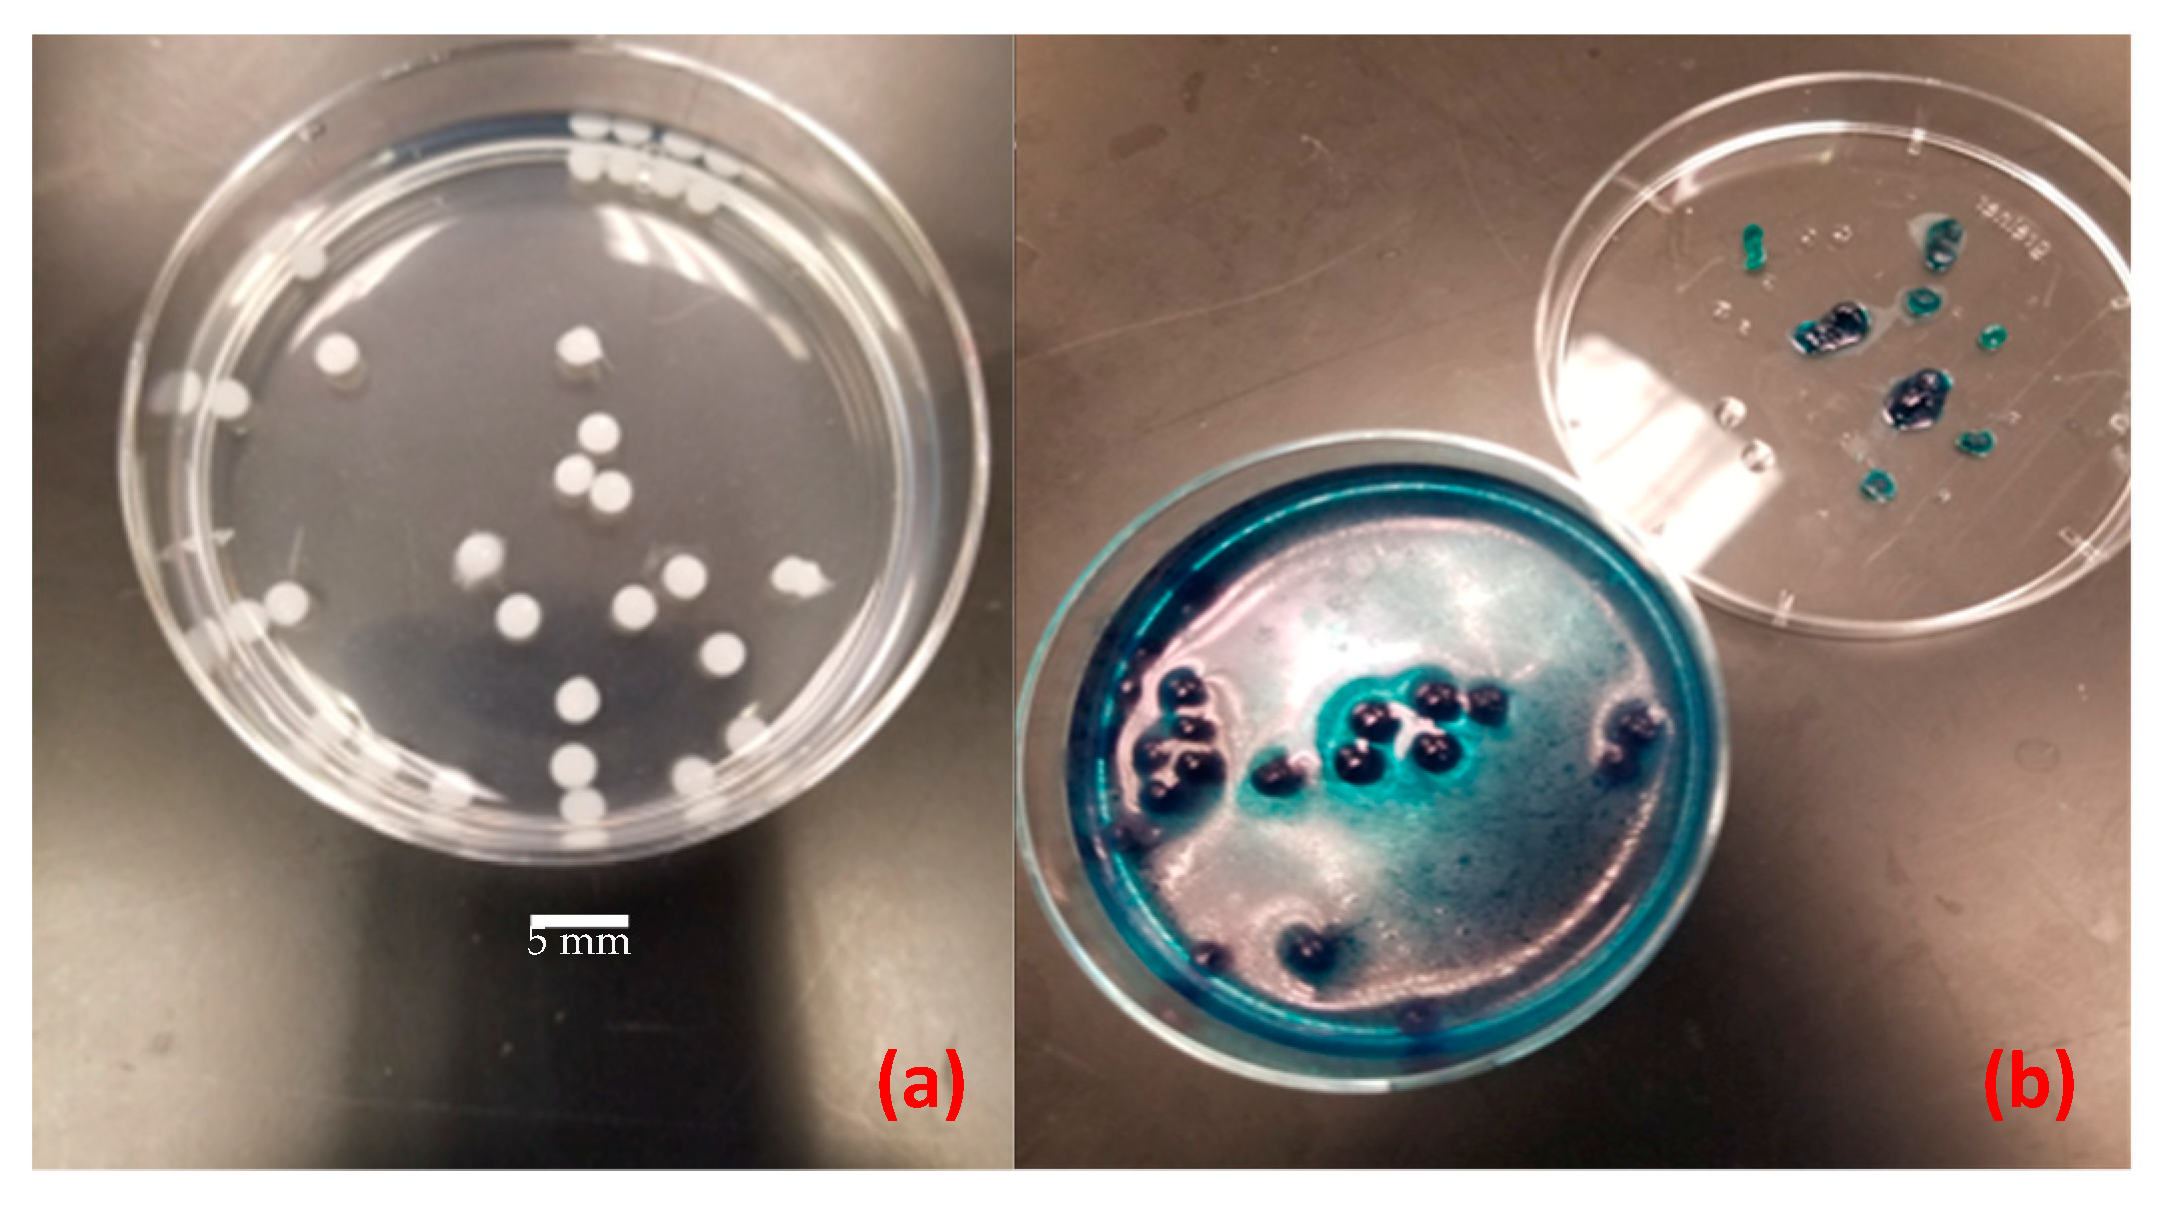
Sensors 20 01145 g004

Sustainable, Alginate-Based Sensor for Detection of Escherichia coli in Human Breast Milk
Abstract
:1. Introduction
2. Materials and Methods
2.1. Materials
2.2. Methods
2.2.1. Cell Preparation
2.2.2. Enzyme Extraction
2.2.3. Hydrogel Assay
Microcapsule Fabrication
Assay Indicators
2.2.4. Monitoring Biomolecular Activity on the Assay
Controls
Categorical Scale for Optimization Runs
Continuous Scale for Lower LOD
2.2.5. Assay Optimization
2.2.6. Assay Development Material Cost
2.2.7. Statistical Analysis
3. Results
3.1. Controls
3.2. Assay Optimization and Confirmation Runs
3.3. LOD Determination
3.4. Assay Development Material Cost
4. Discussion
5. Conclusions and Future Work
Supplementary Materials
Author Contributions
Funding
Acknowledgments
Conflicts of Interest
References
- Wagner, J.; Hanson, C.; Anderson Berry, A. Donor Human Milk for Premature Infants: A Review of Current Evidence. ICAN Infant Child. Adolesc. Nutr. 2013, 5, 71–77. [Google Scholar] [CrossRef] [Green Version]
- Mac, K.; Tromburg, T.M.; Parker, M.T.; Morrison, N.; O’Connor, S.; Weber, C.; Kim, U. Screening donated breast milk in the developing world: Market evaluation and needs identification for rapid and sustainable methods of screening donated milk at human milk banks. In Proceedings of the IEEE Global Humanitarian Technology Conference, San Jose, CA, USA, 19–20 October 2017. [Google Scholar]
- Eidelman, A.I.; Schanler, R.J. Breastfeeding and the Use of Human Milk. Pediatrics 2012, 129, e827–e841. [Google Scholar]
- Kramer, M.S.; Aboud, F.; Mironova, E.; Vanilovich, I.; Platt, R.W.; Matush, L.; Igumnov, S.; Fombonne, E.; Bogdanovich, N.; Ducruet, T.; et al. Promotion of Breastfeeding Intervention Trial Study, G. Breastfeeding and child cognitive development: New evidence from a large randomized trial. Arch. Gen. Psychiatry 2008, 65, 578–584. [Google Scholar] [CrossRef] [PubMed]
- Jones, G.; Steketee, R.W.; Black, R.E.; Bhutta, Z.A.; Morris, S.S.; Bellagio Child Survival Study Group. How many child deaths can we prevent this year? Lancet 2003, 362, 65–71. [Google Scholar] [CrossRef]
- World Health Organization; UNICEF. Acceptable Medical Reasons for Use of Breast Milk Substitutes; World Health Organization: Geneva, Switzerland; UNICEF: New York, NY, USA, 2009. [Google Scholar]
- Kim, J.; Unger, S. Human milk banking. Paediatr Child. Health 2010, 15, 595–602. [Google Scholar] [CrossRef]
- The Surgeon General’s Call to Action to Support Breastfeeding; US Department of Health and Human Services: Washington, DC, USA, 2011.
- Kikuchi, N.; May, M.; Zweber, M. MilkGuard: Low-Cost, Polymer-based Sensor for the Detection of Escherichia coli in Donated Human Breast Milk; Santa Clara University: Santa Clara, CA, USA, 2018. [Google Scholar]
- Infant and Young Child Feeding Chapter, Indian Academy of Pediatric; Bharadva, K.; Tiwari, S.; Mishra, S.; Mukhopadhyay, K.; Yadav, B.; Agarwal, R.K.; Kumar, V. Human milk banking guidelines. Indian Pediatr. 2014, 51, 469–474. [Google Scholar] [CrossRef]
- Bar-Yam, N. Why Is Donor Milk So Expensive? Available online: https://lactationmatters.org/2013/11/08/why-is-donor-milk-so-expensive/ (accessed on 4 February 2020).
- Lewin, A.; Delage, G.; Bernier, F.; Germain, M. Banked Human Milk and Quantitative Risk Assessment of Bacillus cereus Infection in Premature Infants: A Simulation Study. Can. J. Infect. Dis Med. Microbiol. 2019, 2019, 6348281. [Google Scholar] [CrossRef] [Green Version]
- Picaud, J.C.; Buffin, R. Human Milk—Treatment and Quality of Banked Human Milk. Clin. Perinatol. 2017, 44, 95–119. [Google Scholar] [CrossRef]
- Happy Vitals: Tracking Better Health for Mom and Baby. Available online: https://www.prnewswire.com/news-releases/happy-vitals-launches-first-laboratory-direct-to-consumer-home-testing-kit-for-breast-milk-300158235.html (accessed on 4 February 2020).
- Milkscreen Test for Alcohol in Breast Milk. Available online: https://www.upspringbaby.com/collections/breastfeeding-milkscreen (accessed on 4 February 2020).
- NeoGen Tests for Dairy Products. Available online: https://foodsafety.neogen.com/en/dairy (accessed on 4 February 2020).
- Soleris Rapid Microbial Detection. Available online: https://foodsafety.neogen.com/en/soleris (accessed on 4 February 2020).
- Pividori, M.I.; Alegret, S. Biosensors in Quality Assurance of Dairy Products. In Portable Biosensing of Food Toxicants and Environmental Pollutants; Nikolelis, D.P., Varzakas, T., Erdem, A., Nikoleli, G.P., Eds.; CRC Press: Boca Raton, FL, USA, 2013; p. 830. [Google Scholar]
- Ahmed, M.U.; Zourob, M.; Tamiya, E. Food Biosensors; Royal Society of Chemistry: Cambridge, MA, USA, 2017. [Google Scholar]
- Izadi, Z.; Sheikh-Zeinoddin, M.; Ensafi, A.A.; Soleimanian-Zad, S. Fabrication of an electrochemical DNA-based biosensor for Bacillus cereus detection in milk and infant formula. Biosens. Bioelectron. 2016, 80, 582–589. [Google Scholar] [CrossRef]
- Lai, M.; Lai, C.T.; Keating, A.; Dell, J.; Liu, Y. Cross-flow microfiltration for lab-on-chip defatting of human breast milk. Biomedical applications of micro- and nanoengineering IV and complex systems. In Proceedings of the SPIE Smart Materials, Nano- and Micro-Smart Systems, Melbourne, Australia, 9 December 2008. [Google Scholar]
- Park, B.H.; Oh, S.J.; Jung, J.H.; Choi, G.; Seo, J.H.; Kim, D.H.; Lee, E.Y.; Seo, T.S. An integrated rotary microfluidic system with DNA extraction, loop-mediated isothermal amplification, and lateral flow strip based detection for point-of-care pathogen diagnostics. Biosens. Bioelectron. 2017, 91, 334–340. [Google Scholar] [CrossRef]
- Karuppuswami, S.M.; Matta, L.L.; Alocilja, E.C.; Chahal, P. A Wireless RFID Compatible Sensor Tag Using Gold Nanoparticle Markers for Pathogen Detection in the Liquid Food Supply Chain. IEEE Sens. Lett. 2018, 2, 1–4. [Google Scholar] [CrossRef]
- Hossain, S.M.; Ozimok, C.; Sicard, C.; Aguirre, S.D.; Ali, M.M.; Li, Y.; Brennan, J.D. Multiplexed paper test strip for quantitative bacterial detection. Anal. Bioanal Chem. 2012, 403, 1567–1576. [Google Scholar] [CrossRef] [PubMed]
- Gunda, N.S.K.; Dasgupta, S.; Mitra, S.K. DipTest: A litmus test for E. coli detection in water. PLoS ONE 2017, 12, e0183234. [Google Scholar] [CrossRef] [PubMed] [Green Version]
- Morrison, N.; O’Connor, S.; Weber, C. MilkGuard: Low Cost Paper Sensor for the Detection of Escherichia coli in Donated Human Breast Milk; Santa Clara University: Santa Clara, CA, USA, 2017. [Google Scholar]
- Mobed-Miremadi, M.; Asi, B.; Parasseril, J.; Wong, E.; Tat, M.; Shan, Y. Comparative diffusivity measurements for alginate-based atomized and inkjet-bioprinted artificial cells using fluorescence microscopy. Artif. Cells Nanomed. Biotechnol. 2013, 41, 196–201. [Google Scholar] [CrossRef]
- Chang, T.M.S. Artificial Cells: Biotechnology, Nano- medicine, Regenerative Medicine, Blood Substitutes, Bioencapsulation and Cell/Stem Cell Therapy; World Scientific Publishing Co.: Singapore, 2007; Volume 1. [Google Scholar]
- Juers, D.H.; Matthews, B.W.; Huber, R.E. LacZ beta-galactosidase: Structure and function of an enzyme of historical and molecular biological importance. Protein. Sci. 2012, 21, 1792–1807. [Google Scholar] [CrossRef] [Green Version]
- E. coli Cell Culture Concentration from OD600 Calculator. Available online: https://www.chem.agilent.com/store/biocalculators/calcODBacterial.jsp (accessed on 4 February 2020).
- B-PER® Bacterial Protein Extraction Reagent. Available online: https://assets.thermofisher.com/TFS-Assets/LSG/manuals/MAN0011343_BPER_Bacterial_Protein_Extract_Reag_UG.pdf (accessed on 4 February 2020).
- Roy, R.K. Design of Experiments Using the Taguchi Approach; Wiley: New York, NY, USA, 2001. [Google Scholar]
- Coker, J.A.; Sheridan, P.P.; Loveland-Curtze, J.; Gutshall, K.R.; Auman, A.J.; Brenchley, J.E. Biochemical characterization of a beta-galactosidase with a low temperature optimum obtained from an Antarctic arthrobacter isolate. J. Bacteriol 2003, 185, 5473–5482. [Google Scholar] [CrossRef] [Green Version]
- Welsch, N.; Homuth, G.; Schweder, T. Suitability of different beta-galactosidases as reporter enzymes in Bacillus subtilis. Appl. Microbiol. Biotechnol. 2012, 93, 381–392. [Google Scholar] [CrossRef]
- Ballard, O.; Morrow, A.L. Human milk composition: Nutrients and bioactive factors. Pediatr Clin. N. Am. 2013, 60, 49–74. [Google Scholar] [CrossRef] [Green Version]
- Miller, J.H. Experiments in Molecular Genetics; Cold Spring Harbor Laboratory Press: Cold Spring Harbor, NY, USA, 1972. [Google Scholar]
- WaterSafe Bacteria Test Kit. Available online: https://watersafetestkits.com/collections/water-test-kits/products/bacteria-test-kit (accessed on 4 February 2020).
- Jokerst, J.C.; Adkins, J.A.; Bisha, B.; Mentele, M.M.; Goodridge, L.D.; Henry, C.S. Development of a paper-based analytical device for colorimetric detection of select foodborne pathogens. Anal. Chem. 2012, 84, 2900–2907. [Google Scholar] [CrossRef]
- Deiss, F.; Funes-Huacca, M.E.; Bal, J.; Tjhung, K.F.; Derda, R. Antimicrobial susceptibility assays in paper-based portable culture devices. Lab. Chip 2014, 14, 167–171. [Google Scholar] [CrossRef]
- Bisha, B.; Adkins, J.A.; Jokerst, J.C.; Chandler, J.C.; Perez-Mendez, A.; Coleman, S.M.; Sbodio, A.O.; Suslow, T.V.; Danyluk, M.D.; Henry, C.S.; et al. Colorimetric paper-based detection of Escherichia coli, Salmonella spp., and Listeria monocytogenes from large volumes of agricultural water. J. Vis. Exp. 2014, 88, 51414. [Google Scholar]
- Sun, Y.; Quyen, T.L.; Hung, T.Q.; Chin, W.H.; Wolff, A.; Bang, D.D. A lab-on-a-chip system with integrated sample preparation and loop-mediated isothermal amplification for rapid and quantitative detection of Salmonella spp. in food samples. Lab. Chip 2015, 15, 1898–1904. [Google Scholar] [CrossRef] [Green Version]
- Campuzano, S.; Yanez-Sedeno, P.; Pingarron, J.M. Molecular Biosensors for Electrochemical Detection of Infectious Pathogens in Liquid Biopsies: Current Trends and Challenges. Sensors 2017, 17, 2533. [Google Scholar] [CrossRef] [Green Version]
- Wang, J.; Leong, M.C.; Leong, E.Z.W.; Kuan, W.S.; Leong, D.T. Clinically Relevant Detection of Streptococcus pneumoniae with DNA-Antibody Nanostructures. Anal. Chem 2017, 89, 6900–6906. [Google Scholar] [CrossRef]
- Lucas, A.; Roberts, C.D. Bacteriological quality control in human milk-banking. Br. Med. J. 1979, 1, 80–82. [Google Scholar] [CrossRef] [Green Version]
- Almutawif, Y.; Hartmann, B.; Lloyd, M.; Erber, W.; Geddes, D. A retrospective audit of bacterial culture results of donated human milk in Perth, Western Australia. Early Hum. Dev. 2017, 105, 1–6. [Google Scholar] [CrossRef]
- Ng, D.K.; Lee, S.Y.; Leung, L.C.; Wong, S.F.; Ho, J.C. Bacteriological screening of expressed breast milk revealed a high rate of bacterial contamination in Chinese women. J. Hosp. Infect. 2004, 58, 146–150. [Google Scholar] [CrossRef]
- Donor Breast Milk Banks: The Operation of Donor Milk Bank Services; National Institute for Health and Clinical Excellence: London, UK, 2010.
- Madamba, J. Scale Optimization of Milkguard Biosensor for Detecting E. coli in Human Breast Milk; Santa Clara University: Santa Clara, CA, USA, 2019. [Google Scholar]

| Product | Component Detected | Detection Method | Price | Application Setting | Time |
|---|---|---|---|---|---|
| Bacteriological testing [12,13] | Bacillus cereus, Staphylococcus aureus, and enterobacteria | Microbial culturing on agar plates | $35 to $81 to process 100–200 ounces plus labor cost [11] | Commercially available; testing samples sent to lab or testing done on site | 48 h |
| Happy Vitals [14] | Macronutrient levels, heavy metals, vitamins, and minerals | Lab testing by microbiologists | $169.95–$695.95 | Commercially available; lab screening of samples sent from mothers at home | 3–5 days |
| Milkscreen upstring Strips [15] | Alcohol, docosahexaenoic acid | Colorimetric test strip | $14.99 for eight strips | Commercially available; testing at home | 2 min |
| NeoGen tests for dairy products [16] | β-Lactoglobulin (BLG), casein, total milk (casein and whey proteins), and allergens | Screening microwell tests, test strips, lateral flow strips, and microwell enzyme-linked immunosorbent assay (ELISA) tests | Not advertised | Commercially available; used throughout production processes | 30 min |
| Soleris system and vials [17] | Escherichia coli (E. coli) O157:H7 | Ready-to-use vials with colorimetric indicators, incubators, and system software | Not advertised | Commercially available; used throughout production processes | 4–24 h |
| Bioassays for quality assurance of dairy products [18] | Nutrients and pesticides | Temperature, light, and bacteria | >$1000 | Laboratory research, primarily cow milk | Variable |
| Food bioassays [19] | General quality, carcinogen aflatoxin M1 | Optical biosensing of chemiluminescence and fluorescence detection | >$1000 | Laboratory research, primarily cow milk | Variable |
| Electrochemical DNA-based bioassay [20] | Bacillus cereus | DNA-based Au-nanoparticle-modified pencil graphite electrode (PGE) | Low | Laboratory research | Variable |
| Poly(methyl methacrylate) (PMMA) Lab-on-a-chip [21] | Energy content as measured by fat, protein, and lactose | Cross-flow microfiltration structure | Low | Laboratory research | Few minutes-two hours |
| Integrated rotary microfluidic system for point-of-care detection [22] | Salmonella Typhimurium and Vibrio parahaemolyticus | DNA extraction, loop-mediated isothermal amplification, and lateral flow strip | Low | Laboratory research | 80 min |
| Wireless antibody-free biosensor [23] | E. coli C3000 | Radio frequency identification (RFID)-compatible tag using gold nanoparticle markers | Low | Laboratory research | 1 h |
| Runs | BreastMilk Volume | Lysing Time | X-Gal Volume | Contamination Level | Temperature |
|---|---|---|---|---|---|
| A | 0 µL | 10 min | 25 µL | 3.16e7 | 23 °C |
| B | 0 µL | 15 min | 50 µL | 1.00e7 | 37 °C |
| C | 0 µL | 20 min | 75 µL | 1.00e6 | 40 °C |
| D | 0 µL | 25 min | 100 µL | 3.16e5 | 45 °C |
| E | 50 µL | 10 min | 50 µL | 1.00e6 | 45 °C |
| F | 50 µL | 15 min | 25 µL | 3.16e5 | 40 °C |
| G | 50 µL | 20 min | 100 µL | 3.16e7 | 37 °C |
| H | 50 µL | 25 min | 75 µL | 1.00e7 | 23 °C |
| I | 100 µL | 10 min | 75 µL | 3.16e5 | 37 °C |
| J | 100 µL | 15 min | 100 µL | 1.00e6 | 23 °C |
| K | 100 µL | 20 min | 25 µL | 1.00e7 | 45 °C |
| L | 100 µL | 25 min | 50 µL | 3.16e7 | 40 °C |
| M | 150 µL | 10 min | 100 µL | 1.00e7 | 40 °C |
| N | 150 µL | 15 min | 75 µL | 3.16e7 | 45 °C |
| O | 150 µL | 20 min | 50 µL | 3.16e5 | 23 °C |
| P | 150 µL | 25 min | 25 µL | 1.00e6 | 37 °C |
| Variable | Rank | Optimal | Rank | Optimal | Theoretical | Confirmation |
|---|---|---|---|---|---|---|
| I | (S/N) | Recommended | Run (M) | |||
| BreastMilk Volume | 2 | 150 µL | 1 | 150 µL | 150 µL | 150 µL |
| Lysing Time | 5 | 20 min | 5 | 20 min | 20 min | 10 min |
| X-Gal Volume | 4 | 100 µL | 4 | 100 µL | 100 µL | 100 µL |
| Contamination Level | 1 | 3.16e7 | 2 | 3.16e7 | 1.00e7 | 1.00e7 |
| Temperature | 3 | 40 °C | 3 | 40 °C | 40 °C | 40 °C |
© 2020 by the authors. Licensee MDPI, Basel, Switzerland. This article is an open access article distributed under the terms and conditions of the Creative Commons Attribution (CC BY) license (http://creativecommons.org/licenses/by/4.0/).
Share and Cite
Kikuchi, N.; May, M.; Zweber, M.; Madamba, J.; Stephens, C.; Kim, U.; Mobed-Miremadi, M. Sustainable, Alginate-Based Sensor for Detection of Escherichia coli in Human Breast Milk. Sensors 2020, 20, 1145. https://doi.org/10.3390/s20041145
Kikuchi N, May M, Zweber M, Madamba J, Stephens C, Kim U, Mobed-Miremadi M. Sustainable, Alginate-Based Sensor for Detection of Escherichia coli in Human Breast Milk. Sensors. 2020; 20(4):1145. https://doi.org/10.3390/s20041145
Chicago/Turabian StyleKikuchi, Nicholas, Margaret May, Matthew Zweber, Jerard Madamba, Craig Stephens, Unyoung Kim, and Maryam Mobed-Miremadi. 2020. "Sustainable, Alginate-Based Sensor for Detection of Escherichia coli in Human Breast Milk" Sensors 20, no. 4: 1145. https://doi.org/10.3390/s20041145





